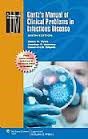
Livro Gantz's Manual Of Clinical Problems In Infectious Disease (lippincott Manua - Myers

ISBN 9786588131350
Edição 1
Ano 2021
Idioma Português
Autor Lippincott
Páginas 320
Encadernação Brochura
Sinopse:
O novo livro de Rachael Lippincott, autora dos best-sellers A cinco passos de você e Todo esse tempo
Emily e sua mãe sempre foram sortudas e tinham uma ligação única. Todo mês escolhiam a mesma cartela da sorte na supercompetitiva noite de bingo da cidade. Até que a sorte da mãe de Emily foi embora há três anos, quando ela sucumbiu a um câncer, e nada pareceu dar mais certo para a garota desde então.
Agora, nas férias antes do último ano escolar, as coisas estão piorando. Emily arruinou o relacionamento com o namorado, Matt, que sua mãe adorava, e seu pai decidiu vender a casa em que ela cresceu. Como se não bastasse, ele ainda convidou Blake, filha de seu melhor amigo, que Emily mal conhece, para ajudá-la a doar todas as coisas da mãe.
Sobre o Autor:
Rachael Lippincott é coautora de "A cinco passos de você", best-seller #1 do New York Times, e de "Todo esse tempo". Ela é bacharel em Inglês pela Universidade de Pittsburgh. Originalmente de Bucks County, Pensilvânia, Rachael atualmente mora em Pittsburgh com sua esposa e seu cachorro, Hank.
Produtos relacionados
-
 Livro Todo Esse Tempo - Brindes Marcadores + Postais - Daughtry/lippincottR$ 54,90até 2x de R$ 27,45 sem jurosou R$ 52,16 via Boleto Bancário
Livro Todo Esse Tempo - Brindes Marcadores + Postais - Daughtry/lippincottR$ 54,90até 2x de R$ 27,45 sem jurosou R$ 52,16 via Boleto Bancário -
 Livro Essential Cancer Pharmacology: The Prescriber's Guide (lippincott Williams - ButlerR$ 498,00até 12x de R$ 41,50 sem jurosou R$ 473,10 via Boleto Bancário
Livro Essential Cancer Pharmacology: The Prescriber's Guide (lippincott Williams - ButlerR$ 498,00até 12x de R$ 41,50 sem jurosou R$ 473,10 via Boleto Bancário -
Livro Gantz's Manual Of Clinical Problems In Infectious Disease (lippincott Manua - MyersR$ 267,00até 12x de R$ 22,25 sem jurosou R$ 253,65 via Boleto Bancário
Livro Gantz's Manual Of Clinical Problems In Infectious Disease (lippincott Manua - MyersR$ 267,00até 12x de R$ 22,25 sem jurosou R$ 253,65 via Boleto Bancário
-
A Livro Pro é uma livraria especializada em livros técnicos e didáticos, com atuação focada nas áreas da saúde, direito, ciências humanas e ciências exatas. Nosso catálogo é cuidadosamente selecionado para atender às necessidades de estudantes, professores, pesquisadores e profissionais, oferecendo obras atualizadas, reconhecidas academicamente e alinhadas às exigências do mercado e da formação educacional. Trabalhamos com conteúdos que apoiam a graduação e pós-graduação até a atualização profissional!













